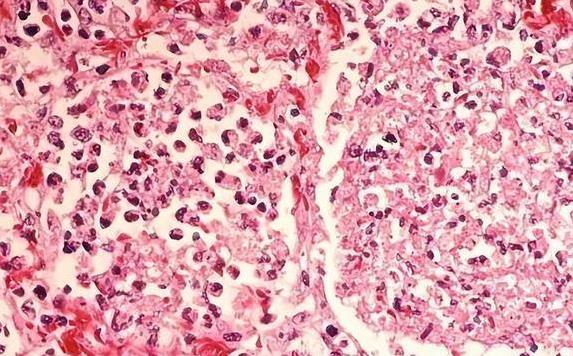

科学家在20亿年前的岩石里找到活微生物!这事儿听起来就像科幻电影,但它真真切切发生了。南非一块古老石头,硬生生藏着活了20亿年的小生命,刷新了人类对地球生命历史的认知。这发现有多牛?直接把已知活微生物的年龄往前推了10亿年!
研究团队在南非东北部的布什维尔德杂岩体挖出了这块宝贝石头。石头表面看着普普通通,但切开一看,里面裂缝附近挤满了微生物群落。科学家用高科技的红外光谱一扫,发现这些小家伙体内还有蛋白质,证明它们还活着,活得好好的!
这些微生物为啥能活这么久?答案藏在它们生活的环境里。布什维尔德杂岩体是个超级稳定的地层,20亿年来几乎没啥大变化。石头里的裂缝就像个天然保护罩,挡住了外界的风吹雨打。微生物们就在这安静的小世界里,慢慢悠悠地活着。
活得慢,是这些微生物的生存秘诀。资源少,它们就省着点用,增殖速度慢得像乌龟爬。科学家估计,它们可能几百年才分裂一次!这种“节能模式”让它们在极端环境下也能撑下去,哪怕氧气少、营养差也没关系。
这块石头不只是个化石,它还是个独立的生态系统。20亿年来,这些微生物没靠外界的阳光、空气,愣是自给自足活下来了。科学家说,这可能是人类发现的存活时间最长的生态系统,堪称地球生命的活历史书。
更厉害的是,这些微生物展示了一个事实:生命在极端环境下也能顽强生存。高温、高压、没吃的没喝的,它们照样活得下去。这让人忍不住想,地球早期那会儿,环境恶劣得像地狱,生命是怎么挺过来的?这些小家伙可能就是答案。
科学家还发现,这些微生物的遗传信息几乎没怎么变。20亿年前啥样,现在还是啥样。这就像打开了一扇窗,让我们能直接偷看地球早期生命的模样。它们的DNA,可能藏着生命起源的秘密!
除了研究地球,这发现还让科学家对宇宙其他星球多了几分期待。既然微生物能在地球深处活20亿年,那火星、木星的卫星,甚至小行星上,会不会也藏着类似的小生命?科学家们已经开始摩拳擦掌,准备拿这些微生物做对比研究了。
想想看,20亿年的生命,硬生生在石头里活到现在。这份顽强,够让人敬佩吧?它提醒我们,生命这东西,比我们想象的要坚韧得多。不管环境多恶劣,总有办法活下去。这不就是一种正能量吗?